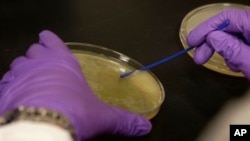

ВАШИНГТОН —
Российские ученые сообщили о том, что, возможно, им удалось обнаружить новые формы жизни в воде антарктического озера Восток, которое в течение 14 миллионов лет было скрыто от окружающего мира. До озера удалось добраться, пробурив почти четырехкилометровую толщу льда, на что с перерывами ушло десять лет.
В воде, забранной из озера в прошлом году, были найдены образцы ДНК бактерий.
Сергей Булат, сотрудник Петербургского Института ядерной физики, сообщил РИА «Новости», что после исключения всех возможных вариантов загрязнения воды, ученые заключили, что обнаруженные в воде бактерии абсолютно уникальны и не похожи ни на одну известную на планете и описанную форму жизни. Пока Булат называет их «неопознанными» и «не классифицированными». Однако для подтверждения открытия понадобится больше образцов.
Британская и американская научные команды также работали над изучением подледных озер в районе Южного полюса. Британцы в прошлом году от дальнейших поисков отказались. Американцы пробурили лед и взяли образцы воды из озера Уилланс. Им также удалось обнаружить «живые клетки». Сейчас продолжается анализ бактерий. Ученые хотят понять, как этим формам удается выживать без воздуха и света, и к какому виду они относятся.
В воде, забранной из озера в прошлом году, были найдены образцы ДНК бактерий.
Сергей Булат, сотрудник Петербургского Института ядерной физики, сообщил РИА «Новости», что после исключения всех возможных вариантов загрязнения воды, ученые заключили, что обнаруженные в воде бактерии абсолютно уникальны и не похожи ни на одну известную на планете и описанную форму жизни. Пока Булат называет их «неопознанными» и «не классифицированными». Однако для подтверждения открытия понадобится больше образцов.
Британская и американская научные команды также работали над изучением подледных озер в районе Южного полюса. Британцы в прошлом году от дальнейших поисков отказались. Американцы пробурили лед и взяли образцы воды из озера Уилланс. Им также удалось обнаружить «живые клетки». Сейчас продолжается анализ бактерий. Ученые хотят понять, как этим формам удается выживать без воздуха и света, и к какому виду они относятся.